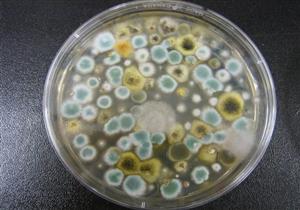
الفرق بين الفطر الأسود والأبيض والأصفر.. أيهم أكثر خطورة؟

أخبار متعلقة بــ
الكوريتزون
-
حقنة الخلطة السحرية لعلاج البرد تسبب أضرارًا خطيرة- مما تتكون؟

يحصل البعض على حقنة الخلطة السحرية لعلاج البرد، دون العلم أن مكوناتها قد تسبب أضرارًا خطيرة، إليك التفاصيل
-
رئيس مكافحة كورونا: انتهاء الوباء في مصر مرهون بهذا الشرط

أكد الدكتور حسام حسني، أن خطورة عدوى كوفيد-19 لا تزال قائمة، رغم تراجع معدلات الإصابة بالوباء العالمي في مصر.
-
حسام موافي يحذر من تريبة الحمام: يسبب مرض خطير

حذر الدكتور حسام موافي، أستاذ الحالات بكلية طب قصر العيني، من تربية الحمام، مشيرًا إلى أنه يشكل خطرًا كبيرًا على صحة الجهاز التنفسي، تحديدًا الرئتين.
-
حساسية الأنف في الشتاء.. طبيب: ليس لها علاج والوقاية هي الحل

يستعرض "الكونسلتو" في التقرير التالي، أسباب حساسية الجيوب الأنفية في الشتاء وطرق السيطرة على أعراضها.
-
"تاج الدين" يوضح العلاقة بين الكوريتزون والإصابة بالفطر الأسود

حذر الدكتور محمد عوض تاج الدين، مستشار الرئيس للشئون الصحية، من تناول الكوريتزون عند الإصابة بفيروس كورونا المستجد دون استشارة الطبيب، مشيرًا إلى أنه من العقاقير المثبطة للمناعة والجرعات العالية منه تقلل من قدرة الجسم
-
الفرق بين الفطر الأسود والأبيض والأصفر.. أيهم أكثر خطورة؟
يبدو أن فيروس كورونا المستجد لا يزال يخبئ في جعبته المزيد من المفاجأت، فبعد اكتشاف الفطر الأسود منذ أيام في الهند، تواجه البلاد الآن نوعين آخرين من الفطريات، وهما "الفطر الأبيض والأصفر"، فما الفرق بين الثلاثة؟ وأيهم
-
الفطر الأسود.. لماذا يُصاب به بعض مرضى كورونا؟

تسود حالة من الذعر والقلق بين المواطنين، بعد اكتشاف الفطر الأسود في مصر بين مرضى فيروس كورونا، مما أثار العديد من التساؤلات حول أسباب الإصابة به وأعراضه وطرق علاجه.
-
عرق النسا الكاذب.. إليك أسباب وأعراض متلازمة الكمثرى وطرق علاجها

بمجرد الشعور بألم في الجزء الخلفي من الفخذين، أول ما يتوارد بذهنك أنك مصاب بعرق النسا، مع العلم أن هناك مرض آخر قد يكون هو المتسبب في المعاناة من هذا العرض المزعج، يعرف باسم "متلازمة الكمثرى" أو "عرق النسا الكاذب".
-
بإسطوانة أكسجين.. "كوثر" تتغلب على مرضها لتلقي لقاح كورونا

رغم الأمراض التنفسية التي تعاني منها كوثر عبد الفتاح، صاحبة الـ68 عامًا، ولكنها توجهت إلى مركز صحة القطامية، صباح اليوم، الخميس، لتلقي لقاح كورونا، وبحوذتها أسطوانة أكسجين متوسطة الحجم، يحملها عنها نجلها أحمد رفقي.
- المزيد
مختارات لا تفوتك
-
 أخبار صحة
أخبار صحةوزارة الصحة: العلاج المناعي يعزز بروتوكولات علاج سرطان الثدي في مصر
وزارة الصحة. العلاج المناعي. بروتوكولات علاج سرطان الثدي. سرطان الثدي. علاج سرطان الثدي في مصر. تطوير علاج سرطان الثدي. الكشف المبكر للمرأة. دعم صحة المرأة.
-
 نصائح
نصائحالعنب في الصيف- ماذا يحدث لمريض ارتجاع المريء عند تناوله؟
العنب في الصيف. العنب لمرضى ارتجاع المريء. العنب والارتجاع المريئي. العنب وارتجاع المريء. العنب وارتجاع المرئ. العنب والحموضة. العنب والمريء. العنب والحموضه.
-
 نصائح
نصائحالغثيان بعد أكل البيض.. تعرف على سببه وكيفية التخلص منه
البيض يسبب غثيان. البيض والقيء. البيض والغثيان. الغثيان بعد أكل البيض. سبب الغثيان بعد أكل البيض. اسباب الغثيان بعد اكل البيض. علاج الغثيان بعد اكل البيض.
-
 أخبار مطبخك الصحي
أخبار مطبخك الصحيوجبة الإفطار لمرضى القولون العصبي- إليك الأطعمة الممنوع تناولها صباحًا
وجبة الفطور لمرضى القولون العصبي. وجبة الفطور لمرضى القولون. وجبة فطور لمرضى القولون العصبي وجبة الافطار لمرضى القولون وجبة الافطار لمرضى القولون وجبة افطار لمرضى القولون
-
 نصائح
نصائحقبل تلف الأعصاب- إليك الأعراض الأولية لنقص فيتامين B12 بالجسم
نقص فيتامين B12. علامات نقص فيتامين B12. أعراض نقص فيتامين B12. نقص فيتامين B12 والأعصاب. أعراض نقص فيتامين B12 على الأعصاب. تأثير نقص فيتامين ب12 على الأعصاب.
-
 نصائح
نصائحأسباب الدوخة عند حركة الرأس- هل تستدعي زيارة الطبيب أم لا؟
الدوخة عند حركة الرأس. الدوخة مع حركة الراس. الدوخة عند تحريك الرأس. اسباب الدوخه مع حركه الراس. أسباب الدوخة عند حركة الرأس. سبب الدوخة مع حركة الراس.
-
 نصائح
نصائحسبب خروج البراز على شكل خيوط- طبيب يوضح الأمراض المحتملة
خروج البراز على شكل خيوط الامراض براز على شكل خيوط. سبب خروج البراز على شكل خيوط. اسباب نزول البراز على شكل خيوط. نزول البراز على شكل خيوط. سبب نزول البراز على شكل خيوط.
-
 أمراض مزمنة
أمراض مزمنةطبيب يحذر: هذا السعال علامة على وجود مشكلة في عضلة القلب
سعال مريض القلب. مريض القلب والكحة. مريض القلب والكحه. كحة مريض القلب. السعال بسبب القلب. الكحه وعلاقتها بالقلب. السعال القلبي. الكحة القلبية. امراض القلب والكحة.
-
 صور و فيديوهات
صور و فيديوهاتمحمد صلاح في كأس العالم- هل يلحق بمباراة أستراليا؟ "فيديوجرافيك"
إصابة محمد صلاح. موقف محمد صلاح من المشاركة في مباراة أستراليا. محمد صلاح في كاس العالم. محمد صلاح في كأس العالم. منتخب مصر في كاس العالم. منتخب مصر في كأس العالم 2026.
-
 صور و فيديوهات
صور و فيديوهاتوفاة طفل في سيارة والده- إليك تفاصيل القصة "فيديوجرافيك"
مأساة التجمع. وفاة طفل في سيارة والده. وفاة طفل داخل سيارة. أب ينسى طفله. أب ينسى طفله داخل سيارة. ضحية النسيان حمزة. الطفل حمزة ضحية النسيان. حمزة ضحية النسيان.











